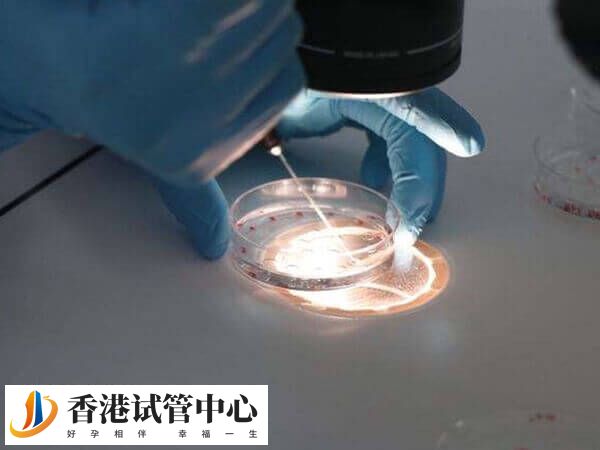
試管養囊要收費

三代試管嬰兒流程是怎樣的
作者:香港試管中心
更新時間:2025-03-15
點擊數:
第三代試管嬰兒共分為4大步驟,即前期檢查、促排卵、胚胎培養和篩查及移植手術等,不同階段助孕方法不同,所以收費也是有所差異的。通常前期檢查費用大概在2000-3000元左右,而促排卵因藥物使用不同,所以收費差異較大,約8千到2萬元不等,具體收費還要以實際為準,不可一概而論。

三代試管的助孕流程及費用
植入前胚胎遺傳學診斷技術俗稱第三代試管嬰兒技術(PGT),是指在胚胎移植前對患者的胚胎進行遺傳學檢測從而挑選出無遺傳學風險的胚胎進行移植,一般患者做三代試管嬰兒助孕流程是怎樣的,其費用是多少,如下所示:
1、前期檢查
不孕不育夫妻需要提前進行全面的檢查以了解雙方具體的身體情況,同時排除不利于三代試管嬰兒的因素后,有效保證三代試管嬰兒的成功率。一般前期檢查收費約2000-3000元不等。
2、促排卵治療
根據女性的年齡、卵巢功能等制定個性化的促排卵方案,以促使卵巢內多個卵泡同時發育。一般促排卵過程中,根據促排使用藥物和方案不同,其收費也是有所差異的,大概在5000-20000元不等。
3、胚胎培養和篩查
促排卵成功后,就可以安排取精取卵了,這時將取出的精子和卵子就能進行體外胚胎培養了,然后從發育到第5天或第6天的囊胚中取出部分細胞進行遺傳學檢測,篩選無遺傳疾病、染色體正常的胚胎,這部分收費大概在1-3萬元不等。
4、移植手術和驗孕
選擇優質的胚胎移植到女性子宮內,移植過程通常不需要麻醉,幾分鐘即可完成。一般在移植14天后,患者在返院抽血查HCG,以明確是否懷孕了,這部分費用約1萬元左右,具體以實際收費為準。





